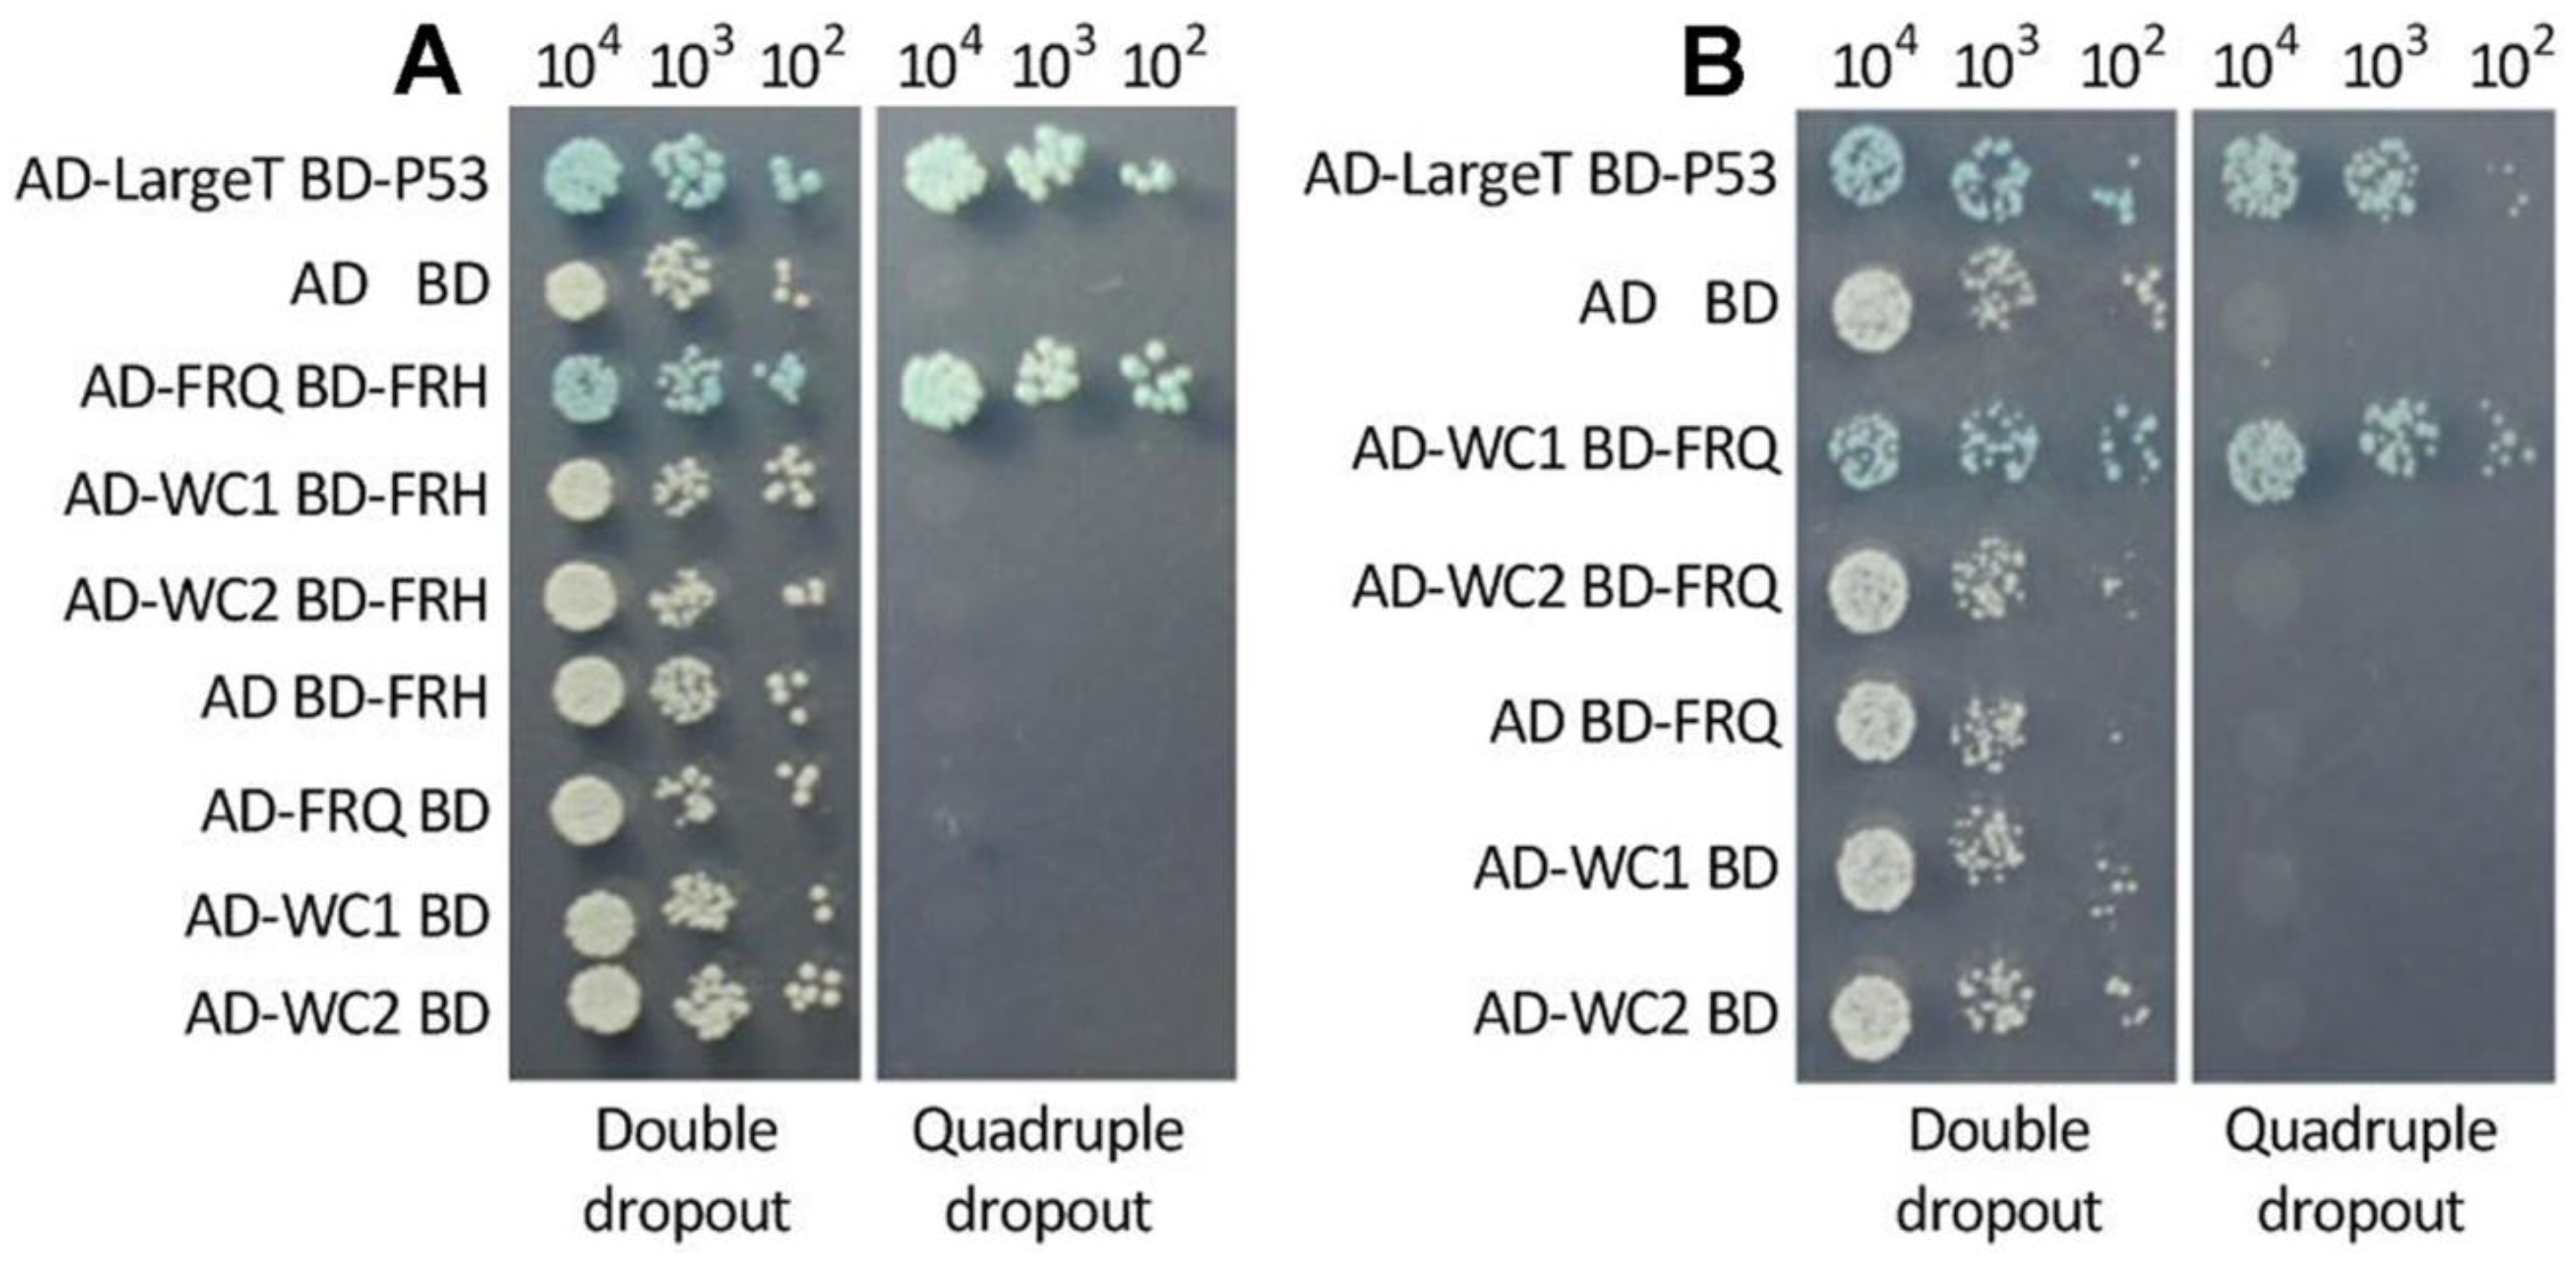
Jof 08 00558 g003

The Essential and the Nonessential Roles of Four Clock Elements in the Circadian Rhythm of Metarhiziumrobertsii
Abstract
:1. Introduction
2. Materials and Methods
2.1. Microbial Strains and Culture Conditions
2.2. Recognition and Bioinformatic Analysis of Fungal FRQ and FRH Orthologs
2.3. Generation of frq and frh Mutants
2.4. Transcriptional Profiling
2.5. Subcellular Localization of FRQ and FRH in M. robertsii
2.6. Y2H Assays
2.7. Observation of Conidiation Rhythm
2.8. Assays for Stress Response, Conidial Yield, UVB Resistance, and Virulence
3. Results
3.1. Structural and Phylogenetic Features of Fungal FRQ and FRH Orthologs
3.2. Transcriptional Profiles and the Subcellular Localization of FRQ and FRH in M. robertsii
3.3. Interactions of FRQ with FRH and WC1
3.4. Circadian Rhythm Is Dependent on FRQ but Independent of FRH
3.5. Dispensable and Limited Roles of FRQ and FRH in the Fungal Lifecycle
4. Discussion
5. Conclusions
Supplementary Materials
Author Contributions
Funding
Institutional Review Board Statement
Informed Consent Statement
Data Availability Statement
Conflicts of Interest
References
- Dunlap, J.C. Molecular bases for circadian clocks. Cell 1999, 96, 271–290. [Google Scholar] [CrossRef] [Green Version]
- Baker, C.L.; Loros, J.J.; Dunlap, J.C. The circadian clock of Neurosporacrassa. FEMS Microbiol. Rev. 2012, 36, 95–110. [Google Scholar] [CrossRef] [PubMed] [Green Version]
- Hurley, J.M.; Loros, J.J.; Dunlap, J.C. Circadian oscillators: Around the transcription-translation feedback loop and on to output. Trends Biochem. Sci. 2016, 41, 834–846. [Google Scholar] [CrossRef] [PubMed] [Green Version]
- Froehlich, A.C.; Liu, Y.; Loros, J.J.; Dunlap, J.C. White Collar-1, a circadian blue light photoreceptor, binding to the frequency promoter. Science 2002, 297, 815–819. [Google Scholar] [CrossRef]
- He, Q.; Cheng, P.; Yang, Y.H.; Wang, L.X.; Gardner, K.H.; Liu, Y. White collar-1, a DNA binding transcriptionfactor and a light sensor. Science 2002, 297, 840–843. [Google Scholar] [CrossRef]
- de Paula, R.M.; Lewis, Z.A.; Greene, A.V.; Seo, K.S.; Morgan, L.W.; Vitalini, M.W.; Bennett, L.; Gomer, R.H.; Bell-Pedersen, D. Two circadian timing circuits in Neurosporacrassa cells share components and regulate distinct rhythmic processes. J. Biol. Rhythm. 2006, 21, 159–168. [Google Scholar] [CrossRef]
- Cheng, P.; He, Q.; Wang, L.; Liu, Y. Regulation of the Neurospora circadian clock by an RNA helicase. Gene Dev. 2005, 19, 234–241. [Google Scholar] [CrossRef] [Green Version]
- Luo, C.; Loros, J.J.; Dunlap, J.C. Nuclear localization is required for function of the essential clock protein FRQ. EMBO J. 1998, 17, 1228–1235. [Google Scholar] [CrossRef] [Green Version]
- Liu, Y.; Garceau, N.Y.; Loros, J.J.; Dunlap, J.C. Thermally regulated translational control of FRQ mediates aspects of temperature responses in the Neurospora circadian clock. Cell 1997, 89, 477–486. [Google Scholar] [CrossRef] [Green Version]
- Colot, H.V.; Loros, J.J.; Dunlap, J.C. Temperature-modulated alternative splicing and promoter use in the circadian clock gene frequency. Mol. Biol. Cell 2005, 12, 5563–5571. [Google Scholar] [CrossRef] [Green Version]
- Diernfellner, A.; Colot, H.V.; Dintsis, O.; Loros, J.J.; Dunlap, J.C.; Brunner, M. Long and short isoforms of Neurospora clock protein FRQ support temperature-compensated circadian rhythms. FEBS Lett. 2007, 581, 5759–5764. [Google Scholar] [CrossRef] [PubMed] [Green Version]
- Diernfellner, A.C.; Querfurth, C.; Salazar, C.; Hofer, T.; Brunner, M. Phosphorylation modulates rapid nucleocytoplasmic shuttling and cytoplasmic accumulation of Neurospora clock protein FRQ on a circadian time scale. Gene Dev. 2009, 23, 2192–2200. [Google Scholar] [CrossRef] [PubMed] [Green Version]
- Crosthwaite, S.K.; Dunlap, J.C.; Loros, J.J. Neurospora wc-1 and wc-2: Transcription, photoresponses, and the origins of circadian rhythmicity. Science 1997, 276, 763–769. [Google Scholar] [CrossRef] [PubMed]
- Froehlich, A.C.; Loros, J.J.; Dunlap, J.C. Rhythmic binding of a WHITE COLLAR-containing complex to the frequency promoter is inhibited by FREQUENCY. Proc. Natl. Acad. Sci. USA 2003, 100, 5914–5919. [Google Scholar] [CrossRef] [Green Version]
- Cheng, P.; Yang, Y.; Heintzen, C.; Liu, Y. Coiled-coil domain-mediated FRQ-FRQ interaction is essential for its circadian clock function in Neurospora. EMBO J. 2001, 20, 101–108. [Google Scholar] [CrossRef] [Green Version]
- Cheng, P.; Yang, Y.; Liu, Y. Interlocked feedback loops contribute to the robustness of the Neurospora circadian clock. Proc. Natl. Acad. Sci. USA 2001, 98, 7408–7413. [Google Scholar] [CrossRef] [Green Version]
- Aronson, B.D.; Johnson, K.A.; Loros, J.J.; Dunlap, J.C. Negative feedback defining a circadian clock: Autoregulation of the clock gene frequency. Science 1994, 263, 1578–1584. [Google Scholar] [CrossRef]
- 18 Denault, D.L.; Loros, J.J.; Dunlap, J.C. WC-2 mediates WC-1–FRQ interaction within the PAS protein-linked circadian feedback loop of Neurospora. EMBO J. 2001, 20, 109–117. [Google Scholar] [CrossRef] [Green Version]
- Hong, C.I.; Ruoff, P.; Loros, J.J.; Dunlap, J.C. Closing the circadian negative feedback loop: FRQ-dependent clearance of WC-1 from the nucleus. Gene Dev. 2008, 22, 3196–3204. [Google Scholar] [CrossRef] [Green Version]
- Baker, C.L.; Kettenbach, A.N.; Loros, J.J.; Gerber, S.A.; Dunlap, J.C. Quantitative proteomics reveals a dynamic interactome and phase-specific phosphorylation in the Neurospora circadian clock. Mol. Cell 2009, 34, 354–363. [Google Scholar] [CrossRef] [Green Version]
- Schafmeier, T.; Haase, A.; Kaldi, K.; Scholz, J.; Fuchs, M.; Brunner, M. Transcriptional feedback of Neurospora circadian clock gene by phosphorylation-dependent inactivation of its transcription factor. Cell 2005, 122, 235–246. [Google Scholar] [CrossRef] [PubMed] [Green Version]
- Schafmeier, T.; Diernfellner, A.; Schafer, A.; Dintsis, O.; Neiss, A.; Brunner, M. Circadian activity and abundance rhythms of the Neurospora clock transcription factor WCC associated with rapid nucleo-cytoplasmic shuttling. Gene Dev. 2008, 22, 3397–3402. [Google Scholar] [CrossRef] [PubMed] [Green Version]
- He, Q.; Cha, J.; Lee, H.C.; Yang, Y.; Liu, Y. CKI and CKII mediate the FREQUENCY-dependent phosphorylation of the WHITE COLLAR complex to close the Neurospora circadian negative feedback loop. Gene Dev. 2006, 20, 2552–2565. [Google Scholar] [CrossRef] [PubMed] [Green Version]
- Diernfellner, A.C.; Schafmeier, T. Phosphorylations: Making the Neurosporacrassa circadian clock tick. FEBS Lett. 2011, 585, 1461. [Google Scholar] [CrossRef] [Green Version]
- Wang, B.; Kettenbach, A.N.; Zhou, X.Y.; Loros, J.J.; Dunlap, J.C. The phospho-code determining circadian feedback loop closure and output in Neurospora. Mol. Cell 2019, 74, 771–784. [Google Scholar] [CrossRef]
- Guo, J.H.; Cheng, P.; Liu, Y. Functional significance of FRH in regulating the phosphorylation and stability of Neurospora circadian clock protein FRQ. J. Biol. Chem. 2010, 285, 11508–11515. [Google Scholar] [CrossRef] [Green Version]
- Cha, J.; Yuan, H.Y.; Liu, Y. Regulation of the activity and cellular localization of the circadian clock protein FRQ. J. Biol. Chem. 2011, 286, 11469–11478. [Google Scholar] [CrossRef] [Green Version]
- Shi, M.; Collett, M.; Loros, J.J.; Dunlap, J.C. FRQ-interacting RNA helicase mediates negative and positive feedback in the Neurospora circadian clock. Genetics 2010, 184, 351–361. [Google Scholar] [CrossRef] [Green Version]
- Hurley, J.M.; Larrondo, L.F.; Loros, J.J.; Dunlap, J.C. Conserved RNA helicase FRH acts nonenzymatically to support the intrinsically disordered Neurospora clock protein FRQ. Mol. Cell 2013, 52, 832–843. [Google Scholar] [CrossRef] [Green Version]
- Lauinger, L.; Diernfellner, A.; Falk, S.; Brunner, M. The RNA helicase FRH is an ATP-dependent regulator of CK1a in the circadian clock of Neurosporacrassa. Nat. Commun. 2014, 5, 3598. [Google Scholar] [CrossRef] [Green Version]
- Conrad, K.S.; Hurley, J.M.; Widom, J.; Ringelberg, C.S.; Loros, J.J.; Dunlap, J.C.; Crane, B.R. Structure of the frequency-interacting RNA helicase: A protein interaction hub for the circadian clock. EMBO J. 2016, 35, 1707–1719. [Google Scholar] [CrossRef] [PubMed] [Green Version]
- Salichos, L.; Rokas, A. The diversity and evolution of circadian clock proteins in fungi. Mycologia 2010, 102, 269–278. [Google Scholar] [CrossRef] [PubMed] [Green Version]
- Tong, S.M.; Wang, D.Y.; Cai, Q.; Ying, S.H.; Feng, M.G. Opposite nuclear dynamics of two FRH-dominated frequency proteins orchestrate non-rhythmic conidiation of Beauveriabassiana. Cells 2020, 9, 626. [Google Scholar] [CrossRef] [PubMed] [Green Version]
- Tong, S.M.; Gao, B.J.; Peng, H.; Feng, M.G. Essential roles of two FRQ proteins (Frq1 and Frq2) in Beauveriabassiana’s virulence, infection cycle and calcofluor-specific signaling. Appl. Environ. Microbiol. 2021, 87, e02545-20. [Google Scholar] [CrossRef]
- Peng, H.; Guo, C.T.; Tong, S.M.; Ying, S.H.; Feng, M.G. Two white collar proteins protect fungal cells from solar UV damage by their interactions with two photolyases in Metarhizium robertsii. Environ. Microbiol. 2021, 23, 4925–4938. [Google Scholar] [CrossRef]
- Fang, W.G.; Zhang, Y.J.; Yang, X.Y.; Zheng, X.L.; Duan, H.; Li, Y.; Pei, Y. Agrobacterium tumefaciensmediated transformation of Beauveriabassianausing an herbicide resistance gene as a selection marker. J. Invertebr. Pathol. 2004, 85, 18–24. [Google Scholar] [CrossRef]
- Gao, Q.; Jin, K.; Ying, S.H.; Zhang, Y.J.; Xiao, G.H.; Shang, Y.F.; Duan, Z.B.; Hu, X.; Xie, X.Q.; Zhou, G.; et al. Genome sequencing and comparative transcriptomics of the model entomopathogenic fungi Metarhiziumanisopliaeand M. acridum. PLoS Genet. 2011, 7, e1001264. [Google Scholar] [CrossRef] [Green Version]
- Jackson, R.N.; Klauer, A.A.; Hintze, B.J.; Robinson, H.; van Hoof, A.; Johnson, S.T. The crystal structure of Mtr4 reveals a novel arch domain required for rRNA processing. EMBO J. 2010, 7, 2205–2216. [Google Scholar] [CrossRef] [Green Version]
- Tong, S.M.; Feng, M.G. Molecular basis and regulatory mechanisms underlying fungal insecticides’ resistance to solar ultraviolet irradiation. Pest Manag. Sci. 2022, 78, 30–42. [Google Scholar] [CrossRef]
- Chen, Y.; Zhu, J.; Ying, S.H.; Feng, M.G. Three mitogen-activated protein kinases required for cell wall integritycontribute greatly to biocontrol potential of a fungal entomopathogen. PLoS ONE 2014, 9, e87948. [Google Scholar]
- Hevia, M.A.; Canessa, P.; Mueller-Esparza, H.; Larrondo, L.F. A circadian oscillator in the fungus Botrytis cinerea regulates virulence when infecting Arabidopsis thaliana. Proc. Natl. Acad. Sci. USA 2015, 112, 8744–8749. [Google Scholar] [CrossRef] [PubMed] [Green Version]
- Shang, Y.F.; Xiao, G.H.; Zheng, P.; Cen, K.; Zhan, S.; Wang, C.S. Divergent and convergent evolution of fungal pathogenicity. Genome Biol. Evol. 2016, 8, 1374–1387. [Google Scholar] [CrossRef] [PubMed] [Green Version]
- Wang, C.S.; Wang, S.B. Insect pathogenic fungi: Genomics, molecular interactions, and genetic improvements. Annu. Rev. Entomol. 2017, 62, 73–90. [Google Scholar] [CrossRef] [PubMed]

Publisher’s Note: MDPI stays neutral with regard to jurisdictional claims in published maps and institutional affiliations. |
© 2022 by the authors. Licensee MDPI, Basel, Switzerland. This article is an open access article distributed under the terms and conditions of the Creative Commons Attribution (CC BY) license (https://creativecommons.org/licenses/by/4.0/).
Share and Cite
Peng, H.; Zhang, Y.-L.; Ying, S.-H.; Feng, M.-G. The Essential and the Nonessential Roles of Four Clock Elements in the Circadian Rhythm of Metarhiziumrobertsii. J. Fungi 2022, 8, 558. https://doi.org/10.3390/jof8060558
Peng H, Zhang Y-L, Ying S-H, Feng M-G. The Essential and the Nonessential Roles of Four Clock Elements in the Circadian Rhythm of Metarhiziumrobertsii. Journal of Fungi. 2022; 8(6):558. https://doi.org/10.3390/jof8060558
Chicago/Turabian StylePeng, Han, Yi-Lu Zhang, Sheng-Hua Ying, and Ming-Guang Feng. 2022. "The Essential and the Nonessential Roles of Four Clock Elements in the Circadian Rhythm of Metarhiziumrobertsii" Journal of Fungi 8, no. 6: 558. https://doi.org/10.3390/jof8060558
APA StylePeng, H., Zhang, Y.-L., Ying, S.-H., & Feng, M.-G. (2022). The Essential and the Nonessential Roles of Four Clock Elements in the Circadian Rhythm of Metarhiziumrobertsii. Journal of Fungi, 8(6), 558. https://doi.org/10.3390/jof8060558

